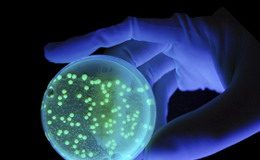

Schlagwort: Tierärzte
Das exklusive Charity-Golfturnier „Gössl Golfer helfen Tieren“ – Tour 2016
Das offene Turnier wurde im Jahr 2015 von Fedor®Tiernahrung in Kooperation mit Gössl Villach zugunsten des Projekts „Tiere helfen Tieren“ ins Leben gerufen. In...
Gelebte Fürsorge für Umwelt und Tier
Wien, März 2015. Am 10. März öffnet das neue Wiener TierQuarTier im 22. Wiener Gemeindebezirk seine Pforten. Rund 450 Hunde, Katzen und Kleintiere werden...
Die neue Tiercommunity, die Mensch und Tier verbindet. Tierscout.at – Ein...
Der Jungunternehmer aus Österreich, Michael Stern (Firma MS Webdesign) gründete 2013 das Internet-Portal „Tierscout.at“ und veröffentlicht am 24. April 2014 die Offizielle Seite derTiercommunity...
Hundepension-Peter die Pension für den Anspruchsvollen Hund
Peter Stephanitsch kümmert sich liebevoll und fürsorglich um jeden einzelnen Hund. Er pflegt sie beschäftigt sie und macht lange Spaziergänge und das im schönem...
Tierversicherung jetzt neu bei Vivema: Der kluge Zweibeiner sorgt vor
Die Produktpalette reicht von einer reinen OP-Versicherung einschließlich Auslandsschutz bis hin zum Rundum-Paket inklusive Gesundheitsvorsorgepauschale und Physiotherapie. Die Wahl des Tierarztes oder der Tierklinik...
Die REHATRON™-Therapie startet 2013 weiter durch
Seit der Erstzulassung 2005 ist die Nicht-invasive Induktions-Therapie mit weltweit ersten Nano-Impuls-System REHATRON alpha zum festen Bestandteil immer mehr innovativ und ganzheitlich arbeitender Praxen,...
Therapiesystem Rehatron alpha auch im internationalen Pferdesport erfolgreich:
Die Nicht-invasive Induktions-Therapie mit Rehatron™alpha, Anfang dieses Jahrtausends von einem österreichischen Team für den Einsatz in der Humanmedizin entwickelt und seither äußerst erfolgreich eingesetzt,...
Mai 2012: Das Webportal von REHATRON™alpha präsentiert sich im neuen Design
Seit Sommer 2011 ist die Novotech Unternehmensgruppe, Linz, Österreich, Hersteller und Rechteinhaber des Nano-Impuls-Systems REHATRON™alpha. Das Gerät zur Nicht-invasiven Induktions-Therapie (kurz: N.I.I.T.), Anfang dieses...
REHATRON™alpha mit neuem Webportal online
Nachdem die Novotech Unternehmensgruppe aus Gallneukirchen bei Linz im Frühsommer 2011 die Hersteller- und Namensrechte an dem medizintechnischen Nano-Impuls-System REHATRON™alpha übernommen hatte, stellt sie...
Die Shiatsu-Praxis Oda Steiner ist mit ihrem neuen Webportal online
Den Begriff „Shiatsu“ verbinden die meisten Menschen nach wie vor mit einem der zahlreichen Aspekte fernöstlicher Heilkunst, deren medizinische Wirkweise letztlich unbewiesen sei und...